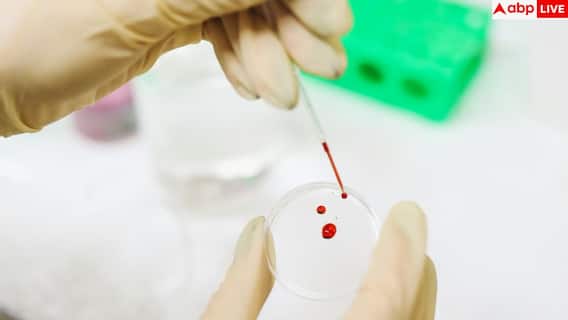

Does Blood Type Affect Personality: शख्सियत को समझने की कोशिश इंसान बहुत पहले से करता आया है. कभी सितारों की चाल देखकर लोगों के स्वभाव का अंदाजा लगाया जाता था, तो कभी किसी खास राशि के नाम पर उनकी खूबियां-कमियां बताई जाती थीं. कह सकते हैं कि इंसानों को अलग-अलग तरह की पर्सनैलिटी में बांटने की आदत लिखित भाषा से भी पहले की है. आज के दौर में हम अपनी पर्सनैलिटी समझने के लिए टेस्ट देते हैं, किताबें पढ़ते हैं या साइकोलॉजी के मॉडल्स पर भरोसा करते हैं. लेकिन एक ऐसा भी पर्सनैलिटी मॉडल है, जो किसी टेस्ट पर नहीं बल्कि सीधे आपके खून पर आधारित है.
इस थ्योरी को जापान में कात्सुएकी-गाता कहा जाता है यानी आपका ब्लड टाइप यह बताता है कि आप कैसे इंसान हैं. दुनिया में आठ तरह के ब्लड ग्रुप पाए जाते हैं और यह सुनने में दिलचस्प लगता है कि आपकी शख्सियत मानो आपके खून में ही लिखी हो. वैज्ञानिक रूप से इतना जरूर सच है कि ब्लड ग्रुप आपकी आनुवंशिक पृष्ठभूमि और परिवारिक इतिहास के बारे में बहुत कुछ बताता है. लेकिन क्या यह सच में आपके स्वभाव को भी तय करता है? इस सवाल का जवाब अभी विज्ञान के पास नहीं हैय
ब्लड-टाइप पर्सनैलिटी थ्योरी की शुरुआत कहां से हुई?
जापान में लंबे समय से यह मान्यता चली आ रही है कि इंसान का ब्लड ग्रुप उसके स्वभाव से जुड़ा होता है. विवाह, रिश्तों या सामंजस्य को आंकने के लिए भी इसे इस्तेमाल किया जाता रहा है.1920 के दशक में जापान के ही एक रिसर्च साइकोलॉजिस्ट टोकेजी फुरुकावा ने एक पेपर छापा क “A Study of Temperament and Blood-Groups” जिसने इस विश्वास को और मजबूत कर दिया. उन्होंने अलग-अलग उम्र के लोगों से 11 सवालों वाला पर्सनैलिटी सर्वे कराया और पाया कि उनके जवाब उनके ब्लड ग्रुप के साथ मेल खाते दिख रहे थे. हालांकि यह रिसर्च बहुत बड़ी नहीं थी, सिर्फ कुछ सौ लोगों पर आधारित. फुरुकावा ने व्यक्तित्व को समझाने के लिए प्राचीन ग्रीक वैद्य हिप्पोक्रेट्स के चार स्वभाव–मॉडल का इस्तेमाल किया. जिसमें
- सैंग्विन (मिलनसार या ऊर्जावान)
- फ्लेग्मैटिक (शांत या संतुलित)
- कोलेरिक (गुस्सैल या जोशीला)
- मेलैंकॉलिक (गंभीर या गहरे विचारों वाला)
उनके मुताबिक
- O ब्लड ग्रुप वाले — शांत और रिलैक्स्ड
- A ब्लड ग्रुप वाले — गंभीर और सोच-समझकर काम करने वाले
- B ब्लड ग्रुप वाले — मिलनसार और चंचल
साइंटफिक आधार कमजोर होने के बावजूद यह थ्योरी जापान और दक्षिण कोरिया की संस्कृति में गहराई से बस गई.
फुरुकावा की मृत्यु के बाद इस पर नए सबूत नहीं मिले, लेकिन 1970 के दशक में जापानी लेखक मसाहिको नोमी ने अपने बेस्टसेलर किताबों से इसे और लोकप्रिय बनाया. उन्होंने दावा किया कि इंसान के स्वभाव का 25 प्रभाव हिस्सा सिर्फ उसके ब्लड टाइप से तय होता है.
क्या इसका वैज्ञानिक प्रमाण है?
सालों की खोज-बीन के बावजूद अब तक कोई वैज्ञानिक सबूत नहीं मिला कि ब्लड टाइप इंसान की पर्सनैलिटी तय करता है. हां, 2013 की कुछ रिसर्च में पाया गया कि कुछ ब्लड ग्रुप खास बीमारियों के प्रति ज्यादा या कम संवेदनशील हो सकते हैं. एक ब्लड-ग्रुप-आधारित डाइट थ्योरी भी लोकप्रिय रही. लेकिन व्यवहार, स्वभाव या सोच पर ब्लड ग्रुप का कोई असर हो ऐसा कोई बड़ा साइंटफिक स्टडी नहीं है. ब्लड टाइप मुख्य रूप यह बताता है कि आपकी रेड ब्लड सेल्स पर कौन-से एंटीजन मौजूद हैं.
- A: A एंटीजन
- B: B एंटीजन
- AB: दोनों एंटीजन
- O: कोई नहीं
यह जानकारी इसलिए जरूरी है क्योंकि ब्लड ट्रांसफ्यूजन यानि खून चढ़ाने में सही ब्लड टाइप जानना जीवनर रक्षक साबित होता है.
इसे भी पढ़ें- Xeroderma Pigmentosum:किस बीमारी की वजह से सिर्फ सूरज की रोशनी में चलता है शरीर, क्या है इस दिक्कत का कारण?
Disclaimer: यह जानकारी रिसर्च स्टडीज और विशेषज्ञों की राय पर आधारित है. इसे मेडिकल सलाह का विकल्प न मानें. किसी भी नई गतिविधि या व्यायाम को अपनाने से पहले अपने डॉक्टर या संबंधित विशेषज्ञ से सलाह जरूर लें.